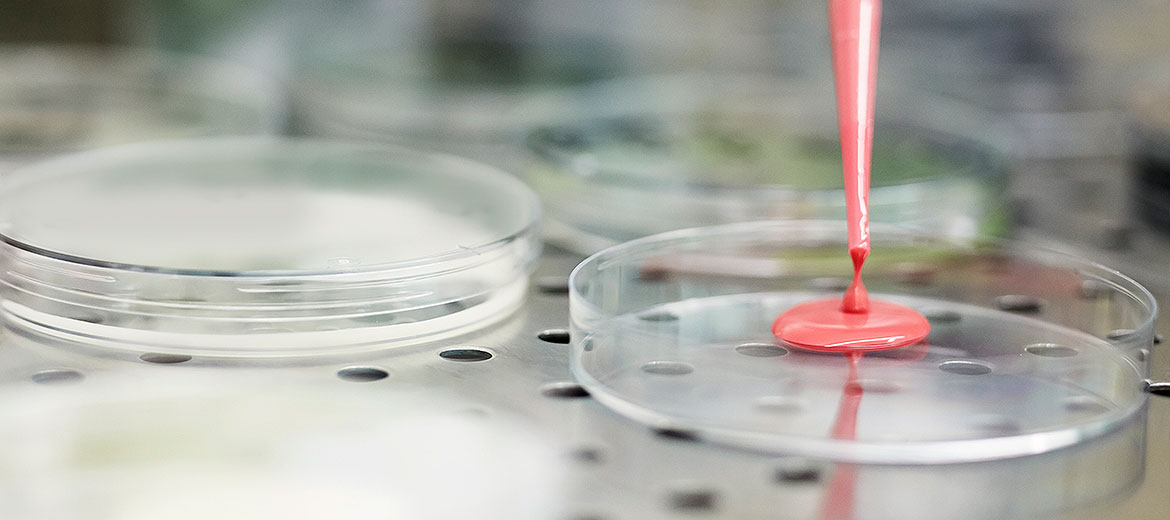
full_image

scientific experts
MORE THAN A SERVICE
When it comes to Research & Development, speed to market is vital, and executing right the first time is critical to success. Drug technology is continuously advancing, and both global regulations and complex formulations make the need for precision increasingly important.The versatility of two-piece hard capsules allow them to be used at every step in the drug development cycle. This obviates the need to switch formulations after initial studies to other dosage forms, therefore decreasing the effort required for stability testing and validation. In the case of limited API products, capsules also reduce losses in small runs. In summary, hard capsules provide a simple way to reduce the workload during development and hence speed up the process from drug discovery, through scale-up and commercialization. (Capsules for Drug Discovery and Development)
Qualicaps® offers a complete spectrum of services surrounding the hard capsules dosage form, able to present our customers with the option of either start-to-finish development or focused support at any critical stage of the drug product’s life cycle. In this line, our scientists and subject matter experts offer a complete line of complimentary services, including:
- Providing R&D support in capsule-form dosage delivery in every stage of drug development, from formulation and analytics to pre-clinical and clinical trials.
- Organizing training sessions regarding in-vitro and in-vivo capsule behaviors
- Assessing the transfer from patented drugs to a generic version



